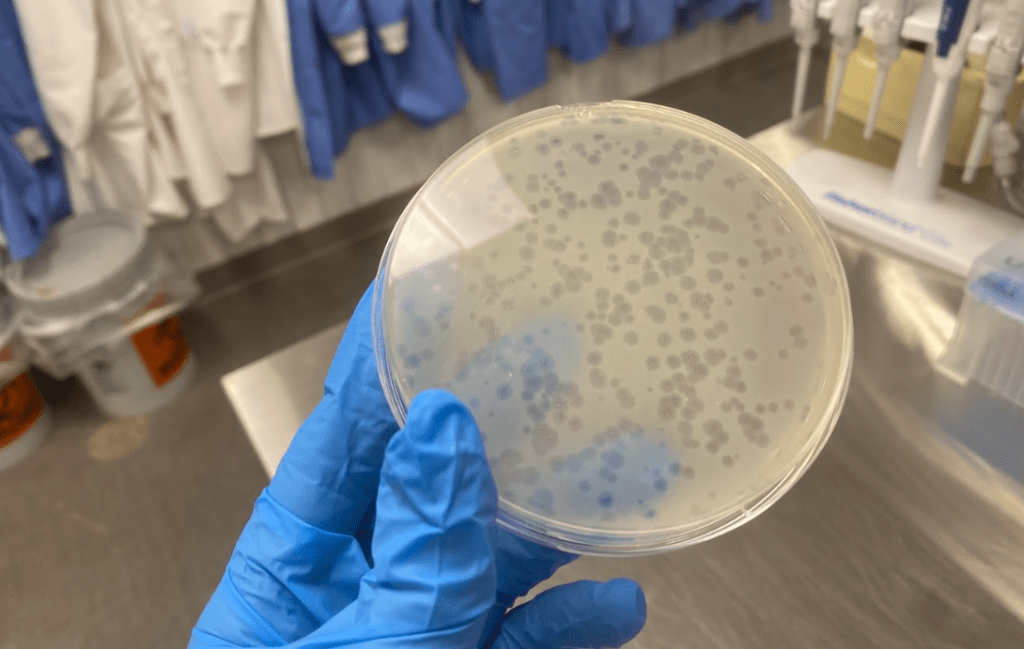

One of the bad ideas that I have in life is doing a PhD. I say this as a bad idea because PhDs are not known to be fun processes that have dubious return values in my industry if you look at it from a market value standpoint (aka can I make more money with this).
But on the other hand I spent my year of graduate school doing research and it was absolute mayhem in the most entertaining way possible. And some days I really just don’t want to think about the idea of spending 40 more years in an office.
(Not to say my current job doesn’t have its excitement. It very much does. But I’m in a bit of a niche position).


And so I just wanted to cover some of the stories from my brief stint in research, and why a position I took to pass the time and get some drinking money grew on me.
The Context
I did research in the environmental and civil engineering department at Michigan. But we were working with folks both at the medical school and public health. My lab worked on sterilizing viruses using cold plasma. It was still purple, but you won’t see it generating fusion anytime soon. The idea being that you could sterilize HVAC vents in a hospital or something or other. I also helped out with a task involving tracking airborne illnesses such as the flu and trying to figure out the environmental factors that caused it to spread faster.


I was assisting PhDs with various tasks in our group, such as tracking the spread of airborne illnesses in classrooms and keeping the electrical equipment running while upgrading it. My own lab was small, 3 of us in total but the lab spaces we used were shared between 5 professors and contained dozens of folks. Albeit I interacted with probably a half dozen consistently.
I worked mainly in between classes and over a summer. My department was all in more or less one giant connected building so it was easy to switch between the two.

The Funny moments
You meet a wide range of undergraduates, masters, PhD, and postdocs when working in a lab and you spend a lot of time working with these people. Because if there’s one thing that’s true about lab it’s that oh my lord it takes forever. You’ll spend hours prepping plates, culturing viruses, and mixing chemicals. And you spend that time talking with the people near you.
One of the people I intended to make my friend was a post-doc named Felipe from Brazil. For context the man was in his 30’s and had a family. Very different stage of life than me. But we were chatting and it came onto the topic of “What was the biggest culture of moving to the US”?
His answer: “Pancakes”.
Not super what I expected but you learn something new every day.
There was also an autoclave in the chemical lab upstairs, which was run by a very (initially) scary man named Tom. And you’d work with him on experiments for various things but I worked with him on an organic throughput scanner to measure ozone. A very fancy machine, costing oh somewhere around $300,000, that could measure the concentration of organic molecules in a sample.
One Thursday night, I was attempting to load the samples and the machine was outputting errors. This was a dual issue.
- The experiment takes 8 hours to run at minimum assuming I don’t have any complications or conflicts. Since this was during the school year not the summer it had taken a bit longer because of class. And if this machine couldn’t run my samples the data would be crap and I would have to redo it.
- It was Thursday night of my last semester of college and I wanted to be out with friends, not in a lab troubleshooting a machine.
So I hit all the override buttons and told the machine to stop being scared and do it’s job. It turned on and then I heard a bit of a hissing sound and “critical error” popped up on the screen.

Turns out an air bubble had jammed the ¼” diameter liquid feed tube and by attempting to override the error I had broken this very expensive machine. The tube had fully shattered. While I contemplated how much Tom was going to kill me I got a call from my roommate Audrey, who was near tears because she dropped one of my $1 shot glasses down the sink and then broke it with the garbage disposal.
Now I probably wasn’t a supportive roommate as I was laughing on the phone over the absurdity of the price difference and how she was more concerned than me but it did bring me back to reality. I managed to put in the spare part from a nearby drawer and saved the run luckily. I told Tom the next day what had happened (the stainless steel tube had sheared in half from the pressure) and he was unamused but also not honestly that mad. As he put it “Crap breaks but for repentance, you’re cleaning the autoclave”.
The autoclave mind you was run constantly and always had agar-like liquids in it that harden. And the seals were caked in it which keeps it pressurized and heated. Which meant I had to clean it. With a screwdriver and chisel-like I was a mason chiseling stone, this stuff was baked in. Not exactly the most glorious way to spend an hour on a Friday morning but I should be thankful it worked out as well as it did.
The Scary Shit
Also before you come at us for an astounding lack of safety, I will say we were far from the worst thing I saw during my time in college. Because if you have a bunch of sleep-deprived idiotic arrogant kids with too much sense for their own good crap is bound to go wrong.
But details are the bones of a story so here we go. The mechanical engineering students had a few lab/manufacturing-based classes they were required to take. Something around the lines of it’s important to actually design and make projects instead of just taking exams. Not a bad idea. It was flawed for a lot of reasons, largely that it just ended up with the kids on out-of-class project teams doing a lot but that’s besides the point.
The point is that they gave Sophomores access to a machine shop and told them to build stuff. It was a competition and there was a timeframe. Which brings us to my teammate from Baja Matt Choi, who was working on getting pieces of sheet metal for their robot done and he was moving over to the bandsaw when he noticed it was acting strange. The coolant was low and the teeth seemed to be skipping.

(Long story short, bandsaw teeth dull over time and like kitchen knives a dull bandsaw is much sketchier than a sharp one).
He told the graduate student who was running the lab, the grad student told him to get working because they were short on time and so he started cutting. To which the saw then jumped and tried to grab onto the nearest thing it could besides the metal it was bouncing off of.
The thing that was grabbed however was Choi’s thumb and started trying to saw through that. He screamed, someone hit the emergency switch and the professor showed up and screamed at the graduate student. Details are vague but I’m pretty sure he got fired.
Choi was then rushed to the hospital where the doctors sewed his now partially dismembered thumb back on, gave him painkillers, and sent him back to the University. Lucky for him the saw had not fully taken his thumb off but had managed to get all the way to the bone.
Two hours after this happens, he’s on painkillers laughing his ass off and telling me (a now very nervous freshman) how I’m going to learn to love this school. He had a good attitude towards life. And as nasty as it sounds. Saws, somewhat bandsaws, but largely table saws: Are notorious for taking fingers off I learned later.

So that wins the award for worst injury I saw at Michigan. Back to the lab.
Lab unlike mechanical engineering, had a virus component. And while most of the viruses we worked with weren’t the deadliest, some were… unideal to get. Mainly the flu. Which I played with a lot.
So to keep it all contained there were a variety of measures we took. All fridges with virus were kept at -80 Fand all supplies were kept at 0 F or lower. The really nasty stuff was contained to a few rooms only, and we tried to keep all the high voltage grounded. But there were three solid scares during my year of working there.
The first is when my own profession screwed over my profession. Aka the street next to the lab blew up. And ok if you didn’t know water mains are pressurized and even a very small pipe (say 4” diameter) can go off with a big explosion if punctured. In this case a much larger one, probably 24” or so, had an unplanned disassembly and detonated the street. The whole thing was flooded, and the road looked like someone had carpet-bombed it.
Pain in the ass for my bus to get home but that’s fine. See the issue came when they tried to repair it, And the repair crew unfortunately had their excavator hit a power bank. Which then took out all the power to the buildings on North Campus. Including our fridges. That contained a lot of virus and were kept at -80.
Now I was not a particularly important person in the whole virus lab game. I was just a masters student. But not everyone came in everyday. And I had the unfortunate luck to be standing in the lab when all the lights went off. And then the fridge alarms went off. The -80 ones we didn’t open. No amount of dry ice we keep for a scenario like this will do crap. But everything else was going to rot or go bad in minutes so everyone in lab started frantically shoving dry ice into the walk-ins. And once that was done both myself and the PhD instructor for a class I was taking realized we were late for class. So we sprinted upstairs to which the professor told us to calm down and it was understandable we were late.

Two hours later the power came on and everything was ok. Then the slack blew up as all the professors who were working from home started blaming each other and sending very unhelpful pointed messages in the channel. What can you do?
The second was the time I was working with a virus sample and I was inspecting the results the day after we ran the experiment. We kept the virus growing with a host on a petri dish and for the sake of scientific accuracy we ran several positive and negative controls. One of these controls was to test antivirals vs the experiments we were doing (using plasma to disinfect it) and when I was looked at my experiment instead of a very dead group of viruses on the antiviral plate I noticed them doing quite well.
Now before I get accused of doing anything horrifically wrong, these viruses couldn’t really jump to humans without a 1 in a million chance. But this is still unideal. We try to avoid making superbugs in the lab. I called over a PhD student named Kate who was much smarter than me and asked what I should do. To which her response was “nuke it in bleach then burn the plate”. To which I happily did.
Bleach burns like hell and it looked like a hibachi grill and flames leapt up a foot above the plate I was holding above the bunsen burner laughing like a lunatic. It was the most serotonin I received in weeks.

The third was when the high voltage grounding broke in our equipment and it arced right in front of myself and my labmates eyes. For the nerds who read this, if any it was 30 kV and 20 amps. More than enough to happily kill a person in under 10 seconds. By far the actually scariest but the quickest.
The Weird Moments
So far you might be wondering if we did any actual science during this time. And fear not we did. You’ll hear about this from anyone who does R&D but I had my own moments of eureka.
One was when we changed the frequency of the plasma generation on accident. I meant to type in hertz and instead typed in kilohertz (1000x times higher). When the results came back with an extra log of inactivation, or 10x as much virus was killed, we didn’t believe our own results and immediately reran the test despite it being finals season to confirm the results.And when we crunched the data to confirm the results it made up the most exciting part of the research that semester. I even got credited on a paper for it. So I can say I’m technically a published author (yay!).
I was also introduced early to the idea of in the adult world, age very much varies. This isn’t like high school or college where someone might be +/- 3 years different from you, but rather a decade older and you’ll be drinking with them. Part of the fun was the graduate students asking how my experience was. The time a graduate student ripped my entire worldview on life apart in a 15 minute drive home just by asking pointed questions like “What do you want?” and people who had already been jaded on academia. This person’s research was entirely stolen by their professor and then published without even mentioning the master’s student who had done all the research. She left for private industry.
And of course I need to mention doing tequila shots with your professor or one of them buying you a drink. Graduate school is very different from undergraduate it turns out (at least at Michigan), and lab work brought me closer with a lot of the professors. Turns out they’re the same nervous and awkward individuals you would expect out of these nerds. But I enjoyed the completely arbitrary shift from undergraduate to graduate, when I went from emailing professors by their last name only to going to the bar with them. There was even a recruitment week for graduate students. Sure it started off normal: You show off the lab, a few speaker panels, and a dinner. Then the department head grabbed all the extroverted grad students they could, handed us a pile of cash and told us to take the perspectives to the nearest bar. Honestly we should’ve picked a nicer bar than we did.

The Frustrating Moments.
Look lab was a ton of fun for all the reasons I mentioned above, but I of course need to say that there were plenty of frustrating moments. Spending hours digging through papers to not find what you want is no one’s idea of a good time. Data would consistently come out to not important and spending hours in the machine shop building parts wasn’t fun. But the hands on aspect, and the constant work towards a tangible goal that’s vaguely morally good was something that I now look for in all my jobs.
I don’t in any way want to glorify the world of PhDs, and the internet is littered with videos of horror stories and people who have quit it. But there’s a certain amount of spice to it that I appreciate. Maybe I’ll go back. Maybe I won’t. Too many options in this world out there.
